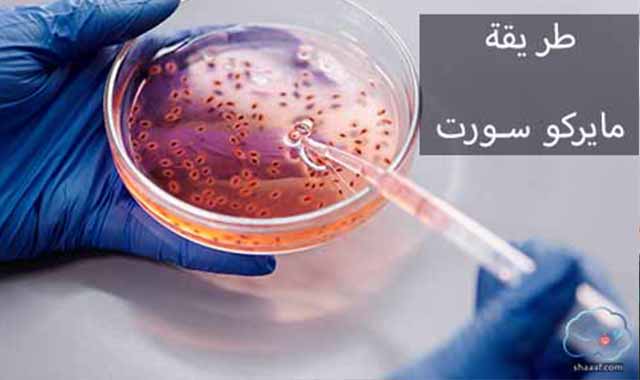
طريقة مايركو سورت تحديد جنس المولود طريقة مايركو سورت تحديد جنس المولود

منذ البداية، كان البشر يبحثون عن طريقة لتحديد جنس المولود الجديد وضمان أنه سيكون صبيًا. حتى بعد عقود، لا يزال مجمع الصبي موجودًا في جميع المجتمعات دون استثناء.
بالإضافة إلى القضية المثيرة للجدل المتمثلة في إعطاء الأولوية للفتيان على البنات، فإن ما يهمنا هو الأساليب والتقنيات التي يمكنها التحكم في جنس الأطفال. معدل الحمل عند الأولاد أو البنات بعد الإخصاب بالطرق الطبيعية.
مثل 50٪ من الأولاد و50٪ من البنات الذين يكون الاتصال الجنسي واحدًا. لكن بعض الناس يريدون تدمير التوازن بين الجنسين، لذلك يستخدمون تقنيات وأساليب، بعضها فعال، والبعض الآخر مجرد خرافات.
إذن ما هي الطريقة الفعالة؟ ما الذي يعتقده أي شخص هو أسطورة عالمية؟
نظرية شتلز في تحديد جنس المولود
![]() |
| نظرية شتلز في تحديد جنس المولود |
تستند نظرية شيتلس إلى فكرة أن الحيوانات المنوية التي تحمل الكروموسوم Y للذكور أسرع من الحيوانات المنوية التي تحمل الكروموسوم X للإناث. لذلك، لتحسين فرصة إنجاب الرجل، يجب على الوالدين ممارسة الجنس قبل الجماع. يوم إباضة الزوجة لا يزيد عن 24 ساعة أو لا يزيد عن 12 ساعة. الإباضة.
وفقًا لهذه النظرية، تزداد فرصة الذكر المخصب لأن الحيوانات المنوية التي تحمل الكروموسوم الذكري تكون أسرع ويمكن أن تصل إلى البويضة ويتم تخصيبها قبل أن يحمل الحيوان المنوي الكروموسوم الأنثوي.
تلعب المواقف في النشاط الجنسي دورًا في هذه النظرية، لذلك يجب اعتماد المواقف لضمان وصول القضيب إلى أكبر احتمال ممكن. إذا أراد الزوجان فتاة، فيمكنهما تبني الوضع التقليدي، ولكن قبل يومين إلى أربعة أيام من تاريخ الإباضة.
وفقًا للأشخاص الذين اختبروها، كانت نظرية شيتلس ناجحة بنسبة 75٪، لكن وفقًا للعلماء، حصلوا على 39٪ من النتائج بعد اختبار النظرية.
ذات صلة: طرق تنشيط المبايض للحمل بتوأم ذكور
نظرية ويلان في تحديد جنس المولود
تتناقض هذه التقنية بشكل حاد مع نظرية شيتلس ، التي تقوم على مبدأ التغيرات البيوكيميائية التي تساعد الحيوانات المنوية ذات الصبغيات الذكرية على الوصول مبكرًا في الدورة الشهرية للإناث.
لذلك يجب على الرجل الذي يريد الحمل أن يقيم علاقة حميمة قبل الإباضة بـ 4 إلى 6 أيام، أما الفتاة التي تريد الحمل فيجب أن تمارس الجنس قبل يومين أو 3 أيام من التبويض، رغم أن الطبيب الذي اخترع هذه التقنية يؤكد نجاحها نسبة الرجال تصل إلى 68٪، وتبلغ نسبة نجاح الفتاة 56٪ لكن الخبراء يشكون في ذلك هذه النسب صحيحة.
الفحص الجيني قبل الزرع
![]() |
| الفحص الجيني قبل الزرع |
على الرغم من أن هذه الطريقة تُستخدم عادةً للأشخاص الذين يعانون من العقم أو الأمراض الوراثية الشديدة، إلا أن بعض الأشخاص لا يزالون يستخدمونها لتحديد جنس الطفل. في الاختبار الوراثي PGD، يتم تخصيب بويضة الأم بالحيوانات المنوية للأب.
ذات صلة: طريقة انجاب توأم إناث
وبعد 3 أو 4 أيام، يتم فحص الجنين الناشئ للتحقق من جنس الجنين، ثم يتم توصيله بشكل صحيح إلى الرحم. بمعنى آخر، يتم اختيار الأجنة التي يريدها الوالدان، ويتم التخلص من الأجنة الأخرى.
هذه الطريقة فعالة بنسبة 100٪، لكنها مكلفة للغاية وغير قانونية في بعض البلدان، لذا يقتصر استخدامها على الأشخاص المصابين بالعقم أو الأمراض الوراثية.
طريقة مايركو سورت تحديد جنس المولود
![]() |
| طريقة مايركو سورت تحديد جنس المولود |
تستند هذه النظرية إلى النظرية القائلة بأن الحيوانات المنوية التي تحمل الكروموسومات الأنثوية أكبر من الحيوانات المنوية التي تحمل الكروموسومات الذكرية. في هذه التقنية، يتم وضع الحيوانات المنوية في أنبوب اختبار وتضاف الصبغة. نظرًا لأن الحيوانات التي تحمل الكروموسومات الأنثوية أكبر، فإنها تستهلك المزيد من الصبغة، مما يعني أنها ستبدو أفتح.
فإذا أراد فتاة فيُعزل ويُزرع في رحم الأنثى؛ إذا كان الهدف ذكرًا، يتم استخدام الحيوانات المنوية ذات الصبغيات الذكرية. معدل نجاحه من 1 إلى 6 وهو مكلف للغاية.
ذات صلة: فوائد الزنجبيل والقرفة للجنس
النظام الغذائي تحديد جنس المولود
هناك العديد من النظريات المتضاربة حول الطعام الذي يجب تناوله لتصور ذكر أو أنثى. لكن النظرية الأكثر شيوعًا هي تناول المزيد من اللحوم الحمراء والأطعمة التي تحتوي على الكثير من الملح لزيادة خصوبة الذكور ، والاعتماد على الأسماك والخضروات والكثير من الشيكولاتة لتلد الفتاة. لا يمكن ضمان نجاح هذا النهج، ولا يوجد دليل علمي يدعمه.
ذات صلة: كيف يمكن زيادة الوزن طبيعيا
من يصل للذروة أولاً رجل أم امرأة
![]() |
| دمن يصل للذروة أولاً رجل أم امرأة |
على الرغم من عدم وجود دليل علمي يدعمها، إلا أنها تقنية شائعة جدًا. بعض الناس يؤمنون بذلك وينسون أنه بدون أي تدخل يكون معدل الحمل لكل من الأولاد والبنات 50٪، والنظرية أنه إذا وصل الرجل إلى النشوة أولاً، يكون المولود ذكراً والعكس صحيح.
الجدول الصيني تحديد جنس المولود
لجدول الصيني يمكنه توقع جنس المولود بالاستناد إلى عمر الأم والشهر الذي حملت فيه. الجدول يبدأ من سن الثامنة عشرة وحتى الـ 45 عاماً. بطبيعة الحال البعض يعتقد أن الجدول يمكنه التوقع بدقة والبعض الآخر يعتبره مجرد طريقة مسلية للتوقع. تجدر الإشارة إلى أن العمر وفق الجدول هو وفق التقويم القمري وعليه يجب إضافة سنة واحدة إلى عمر زوجتك في حال قررت الاعتماد عليه.
ذات صلة: ترهلات البطن بعد الولادة
يمكن لبرنامج الصينيين التنبؤ بجنس الطفل بناءً على عمر الأم وشهر الحمل. تبدأ الساعات من 18 إلى 45 سنة. بالطبع، يعتقد بعض الناس أنه يمكن توقع التقدم بدقة، بينما يعتقد البعض الآخر أن هذه مجرد طريقة توقع مثيرة للاهتمام. وتجدر الإشارة إلى أن العمر حسب الجدول الزمني يعتمد على التقويم القمري، لذا إذا قررت الوثوق بزوجتك، فعليك زيادة عمرها بمقدار عام واحد